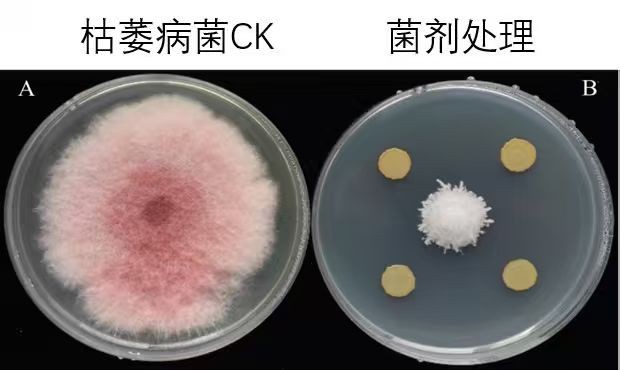
images
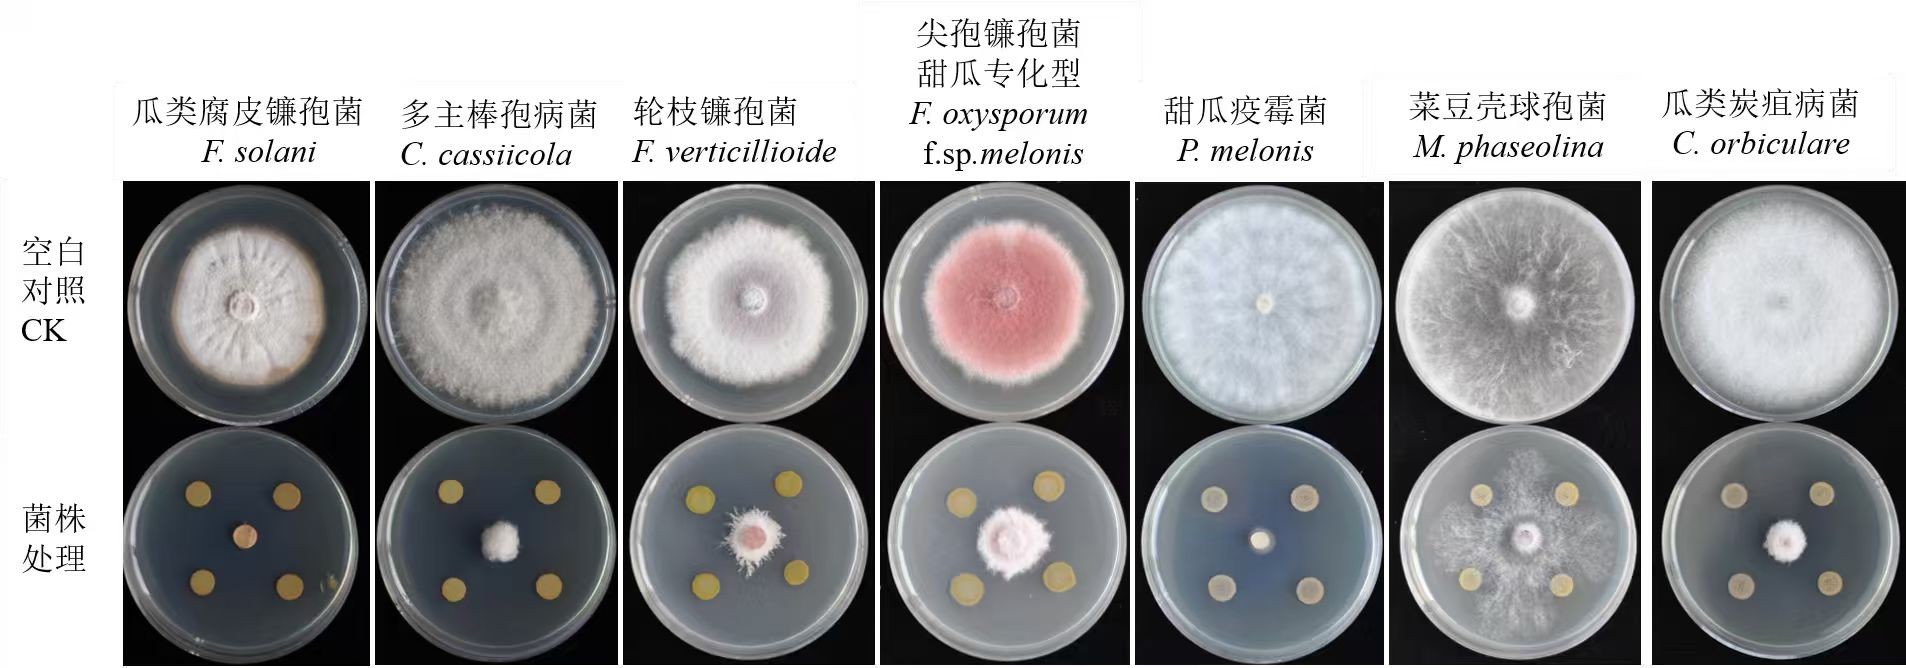
images

郑果所生物防治课题“地美茂”天然橡胶酶解蛋白菌肥每桶20公斤5亩地!
¥360.00
-
郑果丰果树农资商城
- 郑果丰技术依托于中国农业科学院郑州果树研究所,提供专业的果树技术和农资产品!期待和您建立持久深入的合作关系!祝您成功!
- 扫描二维码,访问我们的微信店铺
郑果所生物防治课题“地美茂”天然橡胶酶解蛋白菌肥每桶20公斤5亩地!
1. 打开微信,扫一扫左侧二维码
2. 点击右上角图标

3. 发送给朋友、分享到朋友圈、收藏

1. 打开微信,扫一扫左侧二维码
2. 点击右上角图标

3. 发送给朋友、分享到朋友圈、收藏